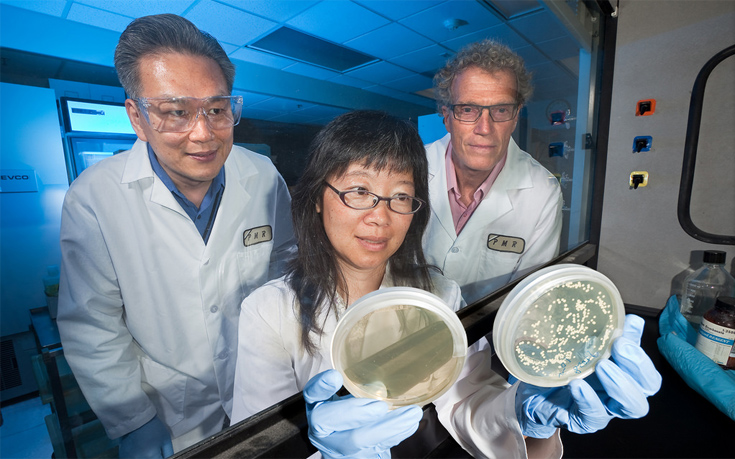

Newly-released government documents suggest that the federal hiring freeze thwarted up to approximately 1,800 agricultural research jobs earlier this year. These numbers were gathered from lists of U.S. Department of Agriculture job vacancies released to the Sierra Club in response to a Freedom of Information Act request.
The jobs range from chemists to geneticists, animal caretakers to soil scientists, immunologists to entomologists. The most common were biological science aides and technicians. Some were high-level -- chief science officer, director of international research programs, and national program leaders for specialty crops and animal and plant health.
People who work at the USDA conduct research that strengthens rural economies. Among the vacant positions were staff who would be studying ways to manage water, soil, pests, livestock, and rangeland. This area of the USDA is also responsible for economic and industry statistics that are used by farmers, businesses, and watchdogs alike.
| Agency | Vacant positions as of 4/10/17 (est.) |
| Agricultural Research Service (ARS) | 1,682 |
| Economic Research Service (ERS) | 10 |
| National Agricultural Statistics Service (NASS) | 77 |
| National Institute of Food and Agriculture (NIFA) | 64 |
Unfortunately, job figures provided by the USDA are not precise. The Agricultural Research Service was quick to point out that it relies "on an extensive population of temporary and seasonal employees." In some USDA offices, open jobs will appear on a different line for every potential performance level at which new hires could be employed.
The vast majority were career positions, as opposed to political appointees who change after each administration. The USDA could not declare which specific jobs were held up by the hiring freeze, though all were vacant as of April 10, two days before the freeze was lifted.
The executive order had exceptions when necessary to meet "public safety responsibilities." Wildland firefighters, for example, continued to get hired by the Forest Service, which is also managed by the USDA.
A skilled political negotiator could use this waiver to argue for exempting immunologists, microbiologists, and pathologists who study how to prevent the spread of disease. Yet many related offices appear to have been undermined by the freeze. A sampling:
| Office | Division | Vacant positions as of 4/10/17 (est.) |
| Food Safety and Enteric Pathogens Research | ARS Midwest Area | 8 |
| Infectious Bacterial Diseases Research | ARS Midwest Area | 7 |
| Virus and Prion Research | ARS Midwest Area | 8 |
| Environmental Microbial & Food Safety Laboratory | ARS Northeast Area | 7 |
| Molecular Characterization of Foodborne Pathogens Research | ARS Northeast Area | 2 |
| Foodborne Toxin Detection and Prevention Research | ARS Pacific West Area | 11 |
| Immunity and Disease Prevention Research | ARS Pacific West Area | 5 |
| Bacterial Epidemiology and Antimicrobial Resistance Research | ARS Southeast Area | 2 |
| Food and Feed Safety Research | ARS Southeast Area | 5 |
Of particular concern are those USDA offices conducting research on bees and other pollinators, who are facing a confluence of events threatening their survival. The Huffington Post spoke with a bee researcher in February who was turned away by the hiring freeze.
| Office | Division | Vacant positions as of 4/10/17 (est.) |
| Bee Research Laboratory | ARS Northeast Area | 5 |
| Honey Bee Research | ARS Pacific West Area | 7 |
| Pollinator Insect Biology, Management, and Systematics Research | ARS Pacific West Area | 3 |
| Honey Bee Breeding, Genetics, and Physiology Research | ARS Southeast Area | 5 |
Even after the federal freeze was lifted, some agencies (including the USDA) continued the practice for certain offices. Tentative job offers made earlier in the year were rescinded, and some open positions were eliminated entirely.
The USDA's frozen jobs are on top of the heavy budget cuts that were proposed by the White House. If the president gets his way, the USDA's discretionary budget would be slashed by 20 percent, making it one of the hardest-hit agencies. The Agricultural Research Service -- or ARS, where most of the government's agricultural science takes place -- would be gutted by 26 percent. ARS would lose 674 full-time staff in 2018, or 1/10th of their workforce.
The Trump administration has been systematically dismantling federal agencies by defunding, deregulating, and understaffing them. The USDA, which serves the interests of Trump's rural base, has not been spared.
There is a way to beat back this tide: Trump has nominated Sam Clovis, a former conservative radio host, to be Under Secretary for Research, Economics, and Education -- the USDA's chief scientist. Clovis was Trump's main agriculture advisor while the hiring freeze and budget process were going on.
Beyond his apparent ineffectiveness at securing agricultural research funding and staffing, his denial of climate change and his bigoted comments make him unfit for any office. Also, he is not a scientist. Please put pressure on your senators to defeat Clovis's nomination.